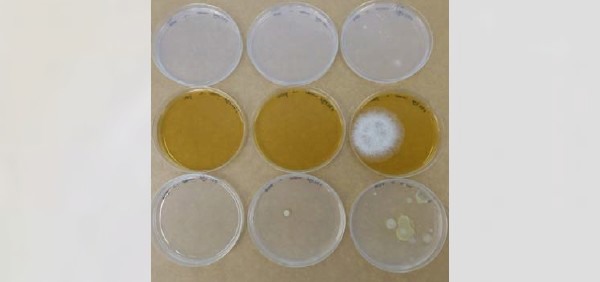

Tholen - Met USAF ultrasone zenders kunnen uitstekend algen worden bestreden, iets dat met het menselijk oog ook daadwerkelijk gezien kan worden. Dat geldt echter niet voor schimmels, en zelfs PCR-testen van watermonsters tonen slechts aan of het DNA van een schimmel aanwezig is, en niet of de schimmel vitaal is of niet. Om zeker te weten of een schimmel een teelt kan aantasten is microscopisch onderzoek noodzakelijk.
Naar aanleiding van een periodieke controle werd er door Eurofins een sterke besmetting met Pythium spp. geconstateerd in een mengsilo van 250m3. De desbetreffende silo bevat vers- en drainwater.
Uit het Eurofins rapport waarin de aanwezigheid van het DNA van de schimmels werd vermeld.
Om hier een mouw aan te passen werden in de mengsilo ultrasone zenders van USAF geïnstalleerd. Dit doodde de Pythium schimmels, maar logischerwijs wilde de teler dit zeker weten. Microscopisch onderzoek bij Eurofins wees inderdaad uit dat de aanwezige Pythium-besmetting geheel onschadelijk was gemaakt, het gevonden DNA van de schimmel was niet meer vitaal.
In totaal is de proef bij Eurofins blijven staan van 2 tot 24 augustus en gedurende deze tijd is er eveneens geen enkel spoor van een mogelijk andere schadelijke schimmel naar buiten getreden. Enkel bevonden zich 2 kleine schimmelkolonies op de platen (zie afbeelding hierboven). In beide gevallen betrof dit, na een nieuwe DNA-test, de schimmel Trichoderma spp., - asperellum en - hamatum. Deze schimmel wordt vaker geconstateerd bij het uitplaten en het is aannemelijk dat deze via de lucht verspreid zijn. Daarnaast betreft het hier een ongevaarlijke schimmel.
Robert de Hoo, eigenaar van Ultramins, is blij met de bevindingen. “Dit is uiteraard een geweldig resultaat en een onomstotelijk bewijs dat onze USAF™ ultrasone zenders zeer effectief te werk gaan. Een sterke concentratie van een zeer schadelijke schimmel kan rampzalige gevolgen hebben voor een teler. Onze zenders bestrijden niet enkel Pythium, maar natuurlijk alle soorten schimmels. Wij bieden een duurzaam alternatief voor chemische middelen en andere mechanische bestrijdingsapparatuur. Onze ultrasone bestrijding werkt 24 uur per dag, 7 dagen in de week en 365 dagen per jaar, vergt geen enkel onderhoud en levert optimaal water. Mocht er een issue met micro-organismen in teeltwater zijn dan komen wij graag in contact, veelal lossen wij de issue op basis van no cure no pay op."

Ultramins uit Zwaag is de exclusieve distributeur van USAF ultrasone zenders. Voor meer informatie kun u contact opnemen met Robert de Hoo op 06-20 536 536 of via [email protected]
USAF is een trademark van Luijxk Ultrasound BV'